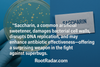
Could Artificial Sweeteners Fight Superbugs? Saccharin’s Surprising Role in Antimicrobial Resistance

by TOM PAGONIS, DDS, MS
Introduction
Root Cause, a recently released Netflix “documentary” film, chronicles the 10-year odyssey of a young filmmaker trying to make sense of his apparent debilitating chronic fatigue and anxiety.
His journey towards understanding and quest for relief takes him through a wide range of testing and therapeutic options. This starts with mainstream medical assessment and continues on to natural supplements, reflexology, kinesiology, homeopathy, aromatherapy, hypnotherapy, psychic readings, spiritual healing, meridian balancing, and intestinal cleansing. This storyline serves as the backdrop to rehash an old and disproven theory of focal infection disease– or that root canal treated teeth are responsible for practically every human chronic degenerative disease including the filmmaker’s particular ailments.
The theory of focal infection disease, which first took root in the late 1800s and early 1900s, postulates that a localized focus of bacteria can disseminate systemically whereby associated bacterial toxins/byproducts are implicated as the cause of several chronic degenerative diseases. Some examples include Hodgkin’s disease, diabetes, neuritis, myalgia, emphysema, asthma, colitis, pancreatitis, osteomyelitis, gastritis, obscure fever, goiter, and brain abscess (1). The fundamental belief of this concept is that disease occurs at a distant organ site from the bacterial focus of infection which itself is clinically asymptomatic or unremarkable. In light of this new film, it is important to review the history of the focal infection theory and its ultimate rejection.
Historic Perspective
Hippocrates may have been one of the first to convey the idea of focal theory when he reported the cure of arthritis after extraction of a tooth (2). Fast forward to the early 1880s when Benjamin Rush, who was both a physician and signatory of the Declaration of Independence, also observed the cure of arthritis (hip) by way of tooth extraction. (2, 3) There was not much traction in Benjamin Rush’s report until Robert Koch, a German physician, and microbiologist, demonstrated the causation of tuberculosis by Myobacterium turberculosis whereby ushering in the golden age of microbiology in the early 1880s. Koch’s introduction to the germ theory of disease caused an avalanche of bacterial-induced disease theories including autointoxication. (2, 4)
In the early 1890’s, William D. Miller, a dentist and physician, published a series of articles (5, 6) (Figure 1) introducing the concept of bacterial etiology of diseased teeth and even proposed the chemoparasitic theory of dental caries. Ironically, he was one of the first to use the term “focus of infection” but did not recommend the removal of teeth to eliminate the bacterial focus, but rather suggested “treating and filling root-canals”. (7)
Figure 1: W.D. Miller’s “The Human Mouth as a Focus of Infection”, 1891
It was not until 1911 when, after a lecture at McGill University that an English physician named William Hunter, promulgated one of darkest periods in dentistry. Together with his lecture (and publications) (8-10), Hunter denounced the restoration of carious teeth, claiming that restorations “built on and about diseased tooth roots form a veritable mausoleum over a mass of sepsis to which there is no parallel in the whole realm of medicine and surgery.” Weston Price, a Canadian dentist, spent nearly 25 years studying pulpless teeth and advocated the extraction of what he claimed to be disease-causing teeth with root canals. His research was largely based on case reports and animal studies in which he claimed to show dramatic improvements from systemic disease after the extraction of non-vital teeth. (11) Price also claimed that if the periodontal ligament was not completely removed during the extraction a jaw bone cavitation could develop which he also identified as a focal point of infection. This period marked a wholesale “orgy” of dental extractions which fortunately began to dissipate in the early 1930s through 1940 when the reexamination of previous publications of focal infection took place. Several studies (3,7) effectively and dramatically recount the research that brought dentistry out of the dark ages. The following quotes (3) accompanying high-quality scientific publications of their time sum up the irreverence towards the disproven focal infection theory of disease:
“If this craze of violent removal goes on, it will come to pass that we will have a gutless, glandless, toothless – and I am not sure that we may not have, thanks to false psychology and surgery – a witless race.” (12)
In a 1942 American Journal of Ophthalmology paper, Woods states: “Stripped of tonsils and teeth, often the victim of colonic irrigation, abdominal, and genito-urinary operations, the patient may finally be reduced to only those organs necessary for existence, while all the time his ocular disease progresses remorselessly to blindness.” (13)
“Focal infection is a splendid example of a plausible medical theory which is in danger of being converted by its enthusiastic supporters into the status of an accepted fact.” (14) As clearly stated on the title of this 1938 publication, Cecil and Angevine analyze the results of 200 cases of rheumatoid arthritis showing no benefit from previously performed tonsillectomies or dental extractions whereby they concluded “the time has arrived for a complete revaluation of the focal infection theory.”
Subsequent studies by Vaizey and Clark-Kennedy in 1939 (15) and Reimann and Havens in 1940 (16) collectively showed, among other things, that the theory of focal infection was not proven, and wholesale extraction of teeth did not cure the diseases which were supposedly caused by endodontically treated teeth.
No Root Cause or Effect
The key points of the above-abbreviated history not only show the evolution and subsequent rejection of the focal infection theory, but it contains the exact type of unscientific thinking used in this film.
Unfortunately, health care professional colleagues providing commentary in this film use the same 70-year-old plus disproven and unsubstantiated claims to fit their narrative - that endodontically treated teeth are the nidus of practically all forms of chronic degenerative diseases. Additional fantastic sounding, cult-like claims and theories are made including the miraculous and instant alleviation of intractable back-pain after failed disc and laminectomy surgery by merely anesthetizing an endodontically treated tooth.
A cardiologist in the film claims that endodontists do not agree that root canal treated teeth are a cause of systemic infection because we (endodontists) need to “claim science rather than belief.” Actually, I would suggest that it is those who continue to hold on to disproven theories that need to “claim science rather than belief.” Indeed, and as part of the commentary in the film states, twenty-five million root canals are performed on an annual basis. The reason for this high number is because the procedure continues to be safe and effective.
The film ends with a saying: new knowledge is never immediately adopted rather the old knowledge dies out and truth takes its place. I could not agree more but believe a more appropriate citation is needed for this film… “Those who cannot learn from history are doomed to repeat it” (George Santayana).
I am glad the filmmaker got his mojo back and is now feeling better with recovered sexual performance after his 10-year odyssey. However, the “root cause” and subsequent recovery from symptoms described was neither related to a successful endodontically treated tooth nor its extraction.
References
1. Roberts HL. Focal infection. Br J Dermato. 33, 353–373, 1921.
2. Francke OC, William Hunter’s “oral sepsis” and American odontology. Bull Hist Dent 21(2):73-9, 1973.
3. Pallasch TJ, Wahl MJ. The focal infection theory: appraisal and reappraisal. J Calif Dental Assoc. 2000 Mar;28(3):194-200.
4. Koch, Robert (10 April 1882). "Die Aetiologie der Tuberculose" [The etiology of tuberculosis]. Berliner Klinische Wochenschrift (Berlin Clinical Weekly). 419: 221–30, 1882.
5. Miller WD, The human mouth as a focus of infection. Dent Cosmos 33:689-713, 1891.
6. Miller WD, The disinfection of dental and surgical instruments. Dent Cosmos 33: 514-26, 1891.
7. Pallasch TJ, Wahl MJ: Focal infection: new age or ancient history? Endodontic Topics 2003; 4, 32-45.
8. Hunter W, Oral sepsis as a cause of disease. Br Med J 215-6, 1900.
9. Hunter W, The role of sepsis and of antisepsis in medicine. Lancet 1:79-86, 1911.
10. Hunter W, The role of sepsis and antisepsis in medicine and the importance of oral sepsis as its chief cause. Dent Register 65: 577-611, 1911.
11. Baumgartner, J. Craig; Siqueira, Jose F.; Sedgley, Christine M.; Kishen, Anil (2007), "Microbiology of Endodontic Disease", Ingle's Endodontics (6 ed.), PMPH-USA.
12. Kopeloff N, Why Infections? Alfred A Knopf, London, 1926.
13. Woods AC, Focal infection. Am J Ophthalmol 25:1423, 1942.
14. Cecil RL, Angevine DM, Clinical and experimental observations on focal infection with an analysis of 200 cases of rheumatoid arthritis. Ann Int Med 12(5):577-84, 1938.
15. Vaizey JM, Clark-Kennedy AE, Dental sepsis in relation to anaemia, dyspepsia, and rheumatism with particular reference to treatment. Br Med J 12:1269-83, 1939.
16. Reimann HA, Havens WP, Focal infection and systemic disease: A critical appraisal. J Am Med Assoc 114(1):1-6, 1940.